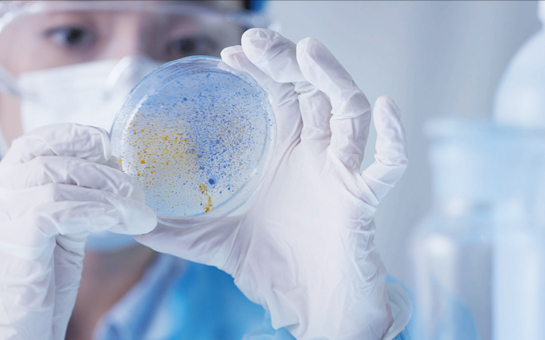
바이오 산업을 선도하는 백신공정 전문교육

인천 바이오 정책
"인천, 글로벌 바이오 허브 도시로 도약하다"
코로나19가 확산일로에 있는 지금 상황에서 향후 바이오산업의 중요성은 아무리 강조해도 지나침이 없다. 바이오산업은 부가가치가 높고, 일자리 창출 효과가 커 미래 성장동력 산업으로 주목받고 있다. 인천시는 2030년까지 송도 11공구를 중심으로 클러스터를 확장하고 바이오산업을 집중 육성하는 정책을 펼칠 계획이다.

인천시는 ‘바이오공정 인력양성센터 구축사업’의 설계공모를 시작으로 바이오산업을 본격화한다. 지상 4층, 연면적 6,600㎡ 규모로 신축되는 ‘바이오공정 인력양성센터 구축사업’의 설계공모는 지난 8월 26일부터 시작됐으며, 접수는 10월 27일까지다. 2024년 1월 개소를 목표로 오는 11월에 당선자를 선정해 기본 및 실시설계를 거쳐 2022년 하반기 착공할 계획이다.
바이오공정 인력양성센터는 바이오산업의 의약품 제조·생산 공정과정에 필요한 전문 인력을 양성하는 국책교육기관이다. 2020~2025년까지 6년간 1,398억 원이 투입되며, 국비 527억 원과 시비 192억 원 외에 연세대가 부지 제공 및 추가 건물 신축을 위해 679억 원을 투입할 계획이다.
바이오공정 인력양성센터 사업현황
- 사업기간 : 2020∼2025년(6년)
- 사업위치 : 연세대 국제캠퍼스 부지(송도동 162-1)
- 사업내용 : GMP 수준의 시설을 갖춘 바이오공정 실습장 구축 및 NIBRT 교육프로그램 도입 등을 통해 연간 2,000명 전문 인력 양성
- 사업추진체계 : 인천시(구축), 인천TP(운영), 연세대학교(교육)
- 추진일정
- 설계공모 및 작품접수 : 2021. 8. ~ 10.
- 작품심사 및 결과발표 : 2021. 11.
- 기본 및 실시설계 : 2021. 11. ~ 2022. 4.
- 공사추진 : 2022. 6. ~ 2023. 10.
- 바이오공정 인력양성센터 개소 : 2024. 1.
인천시는 2023년까지 센터를 완공한 후, 2024년부터 본격적인 교육 프로그램 운영을 통해 연간 2,000여 명의 교육생을 배출할 계획이다.
바이오공정 인력양성센터 구축과 백신교육도 함께 이루어진다. 교육은 ‘한국형 NIBRT 프로그램’ 운영으로 아일랜드 바이오의약품 인력양성기관인 NIBRT의 교육시스템을 우리나라 실정에 맞춰 진행한다. 바이오공정분야 시범교육은 11월부터 진행될 계획이며, 실시 전 백신공정 전문교육이 먼저 진행된다. 교육과정은 기초, 심화, 백신특화 등 총 3개의 이론강의 교육강좌와 배양, 정제, 완제, 분석, 유틸리티 등 총 5개 모듈의 실습교육으로 이루어져 있다. 이론교육은 온라인으로, 실습교육은 현장실습으로 진행될 예정이다. 교육은 9월 6일부터 12월 24일까지 전문대학 이상 졸업한 자를 대상으로 기수별로 30명씩 총 4회에 걸쳐 120명을 교육할 계획이다.인력양성센터가 개소해 본격 가동될 경우 인천 송도에 위치한 관련분야 국내 대기업과 해외기업들이 우수한 인재를 공급받을 수 있을 전망이다. 또 국내 뿐 아니라 동아시아의 전문 인력 수요에 대응하는 한편, 인천 바이오산업 발전에 중추적인 성장 동력 역할을 할 것으로 기대된다.
바이오공정분야 교육
- 백신공정개발
- 교육일정 : 9.6.∼12.24.(4회)
- 교육과정 : 3개의 강의교육강좌, 5개 모듈별* 실습교육(생명공학 Ⅰ·Ⅱ, 백신심화)
*배양,정제 완제, 분석Utility
- 교육인원 : 120명(30명/1기)
- 교육방법 : 온라인 수업(이론교육) 현장실습교육
- 강사진구성 : 바이오공정 교수 + 성백린 교수 외 2명
- 바이오공정
- 추진일정 : 11.22.∼12.17.(3회)
- 교육과정 : 2개의 강의교육강좌(생명공학 Ⅰ, Ⅱ)
- 교육인원 : 120명(40명/1기)
- 교육방법 : 온라인 수업(이론교육)
- 강사진구성 : 정진현 교수 외7명(바이오)
- 교육대상 : 취업준비생, 재직자 등(전문대학 졸업 또는 그에 상응하는 자)
- 교육장소 : 연세대 국제캠퍼스 시범교육장(NIBRT 시범교육장)
- 교육비 : 이론교육 무료(온라인), 실습교육 유료(구직자 50만 원, 재직자 75만 원)
- 추진계획 : 2021.8.∼12.: 백신공정 교육생 기수별 모집 및 교육실시(4회 120명)

바이오산업의 원·부자재 국산화를 위한 준비도 원활하게 진행되고 있다. ‘바이오 원부자재 국산화 30 프로젝트’는 바이오 분야 원부자재의 국내 생산을 위해 관내 중소기업의 사업화(국산화와 수출산업화), 컨설팅 등을 체계적으로 지원하는 내용을 담고 있다. 이에 따라 바이오 의약품을 생산하는 셀트리온, 삼성바이오로직스 등 대기업들은 바이오 원·부자재의 국산 제품 사용을 활성화하고 바이오협회·인천상공회의소·인천테크노파크 등 지원기관은 국산화를 촉진하기 위한 기술개발 및 제도개선을 실시한다. 인천시는 바이오산업 육성 기반구축 및 행정적 지원 역할을 맡게 된다.
인천시는 올해 3억 원의 예산을 수립하였고, 인천상공회의소와 거버넌스를 구축해 참여 기업을 발굴하는 등 구체적 실행에 나선다. 먼저 기업 설문조사와 실무협의회를 운영한 결과를 바탕으로 인천시 제조업체를 대상으로 바이오 분야 국산화 추진업체를 선정할 계획이다. 국산화 컨설팅 지원과 원부자재 생산 기업 제품의 판로개척, 바이오 수요기업과의 협력, 생산기업과의 매칭 등을 추진할 예정이다.
바이오 원부자재 국산화 30 프로젝트
- 인천시 : 바이오산업 육성 기반구축 및 행정적 지원
- 바이오기업(셀트리온·삼성바이오·바이넥스·디엠바이오) : 바이오 원부자재의 국산 제품 사용 활성화
- 바이오협회(한국바이오협회·한국바이오의약품협회), 지원기관(인천상공회의소·인천테크노파크) : 국산화를 촉진하기 위한 기술개발 및 제도개선
혁신성장의 메카
인천 스타트업파크
[인천 스타트업파크]
- 주소 : 인천시 연수구 컨벤시아대로 204
- 주요시설 :
- 인스타Ⅰ(공공주도 혁신기업 육성공간)
- 인스타Ⅱ(민간주도 혁신기업 육성공간)
- 인스타Ⅲ(업무지원, 편의시설)
- 더좋은운동으로
- 시큐레터(주)
- 위셀글로벌 주식회사
- (주)아이미마인
- (주)알에프아이오티
- 주식회사 뉴잇
- 웰펩 주식회사
- 몬드리안에이아이 주식회사
- 에피조딕
- 주식회사 무진비앤에이치
- 주식회사 제이치글로벌
- (주)아쎄따
- 지브레인
- 주식회사 펍플
- 주식회사 지금여기
- (주)에스티에스바이오
- 클로버스튜디오
- 위드펀드
- 주식회사 하벤
- 주식회사 웨인
- (주)오투오
- 주식회사도터
- 위드라이브
- 피크닉파트너스
- 루다큐어 주식회사
- (주)코어사이트
- 주식회사 빵야네트웍스
- 주식회사 이안에스아이티
- (주)크루티브
- 주식회사 에이치엔노바텍
- 주식회사 모빅랩
- 인덱스마인
- 올웨이즈코퍼레이션
- (주)지와이네트웍스
- 스마일시스템 주식회사

[공공주도 혁신기업 육성공간, 인스타Ⅰ]
- 주관 : 인천경제자유구역청
- 대행 : 인천테크노파크
- 예산 : 연 89억 원(시비100%)
- 프로그램 : 실증, 투자, 글로벌 진출
- pasamedi
- 주식회사 움틀
- (주)에너지마이닝
- 소테리아
- 셀트리온
- (주)피트릭스
- 주식회사콜라비팀
- 디씨엔바이오
- (주)프로키언
- (주)건강한친구
- 액티브레인바이오(주)
- 주식회사 카이미
- 단비코리아
- xpanner
- 주식회사 에이트테크
- 빛글림
- 주식회사 쉐코
- 주식회사 카이미
- (주)엘메카
- (주)나인와트
- 주식회사 브라이트랩
- 로지브라더스
- (주)에너지마이닝
- 펫잇
- (주)브레인기어
- (주)피트릭스
- 주식회사 케이비자
- 에바
- (주)프로키언
- 리치앤리치
- 코코넛사일로 주식회사
- (주)나인와트
- 메이크미업 주식회사
- 제이앤피메디
- 주식회사 쉐코
- (주)모두플랫폼
- (주)증강지능
- (주)에너지마이닝
- (주)아이케어닥터
- 크레파스솔루션
- (주)피트릭스
- 주식회사 카버샵
- (주)알앤디아시아
- (주)프로키언
- 주식회사 프롭웨이브
- 비바이노베이션
- (주)나인와트
- 주식회사 네오스텍
- QSTAG
- 주식회사 쉐코

[민간주도 혁신기업 육성공간, 인스타Ⅱ]
- 사업명칭 : 신한 스퀘어브릿지
- 주관 : 신한금융지주 협업 셀트리온그룹
- 예산 : 연 30억 원(펀드 500억 원, 현물 49억 원(셀트리온)
- 프로그램 : 인큐베이션, 액셀러레이팅, 글로벌



